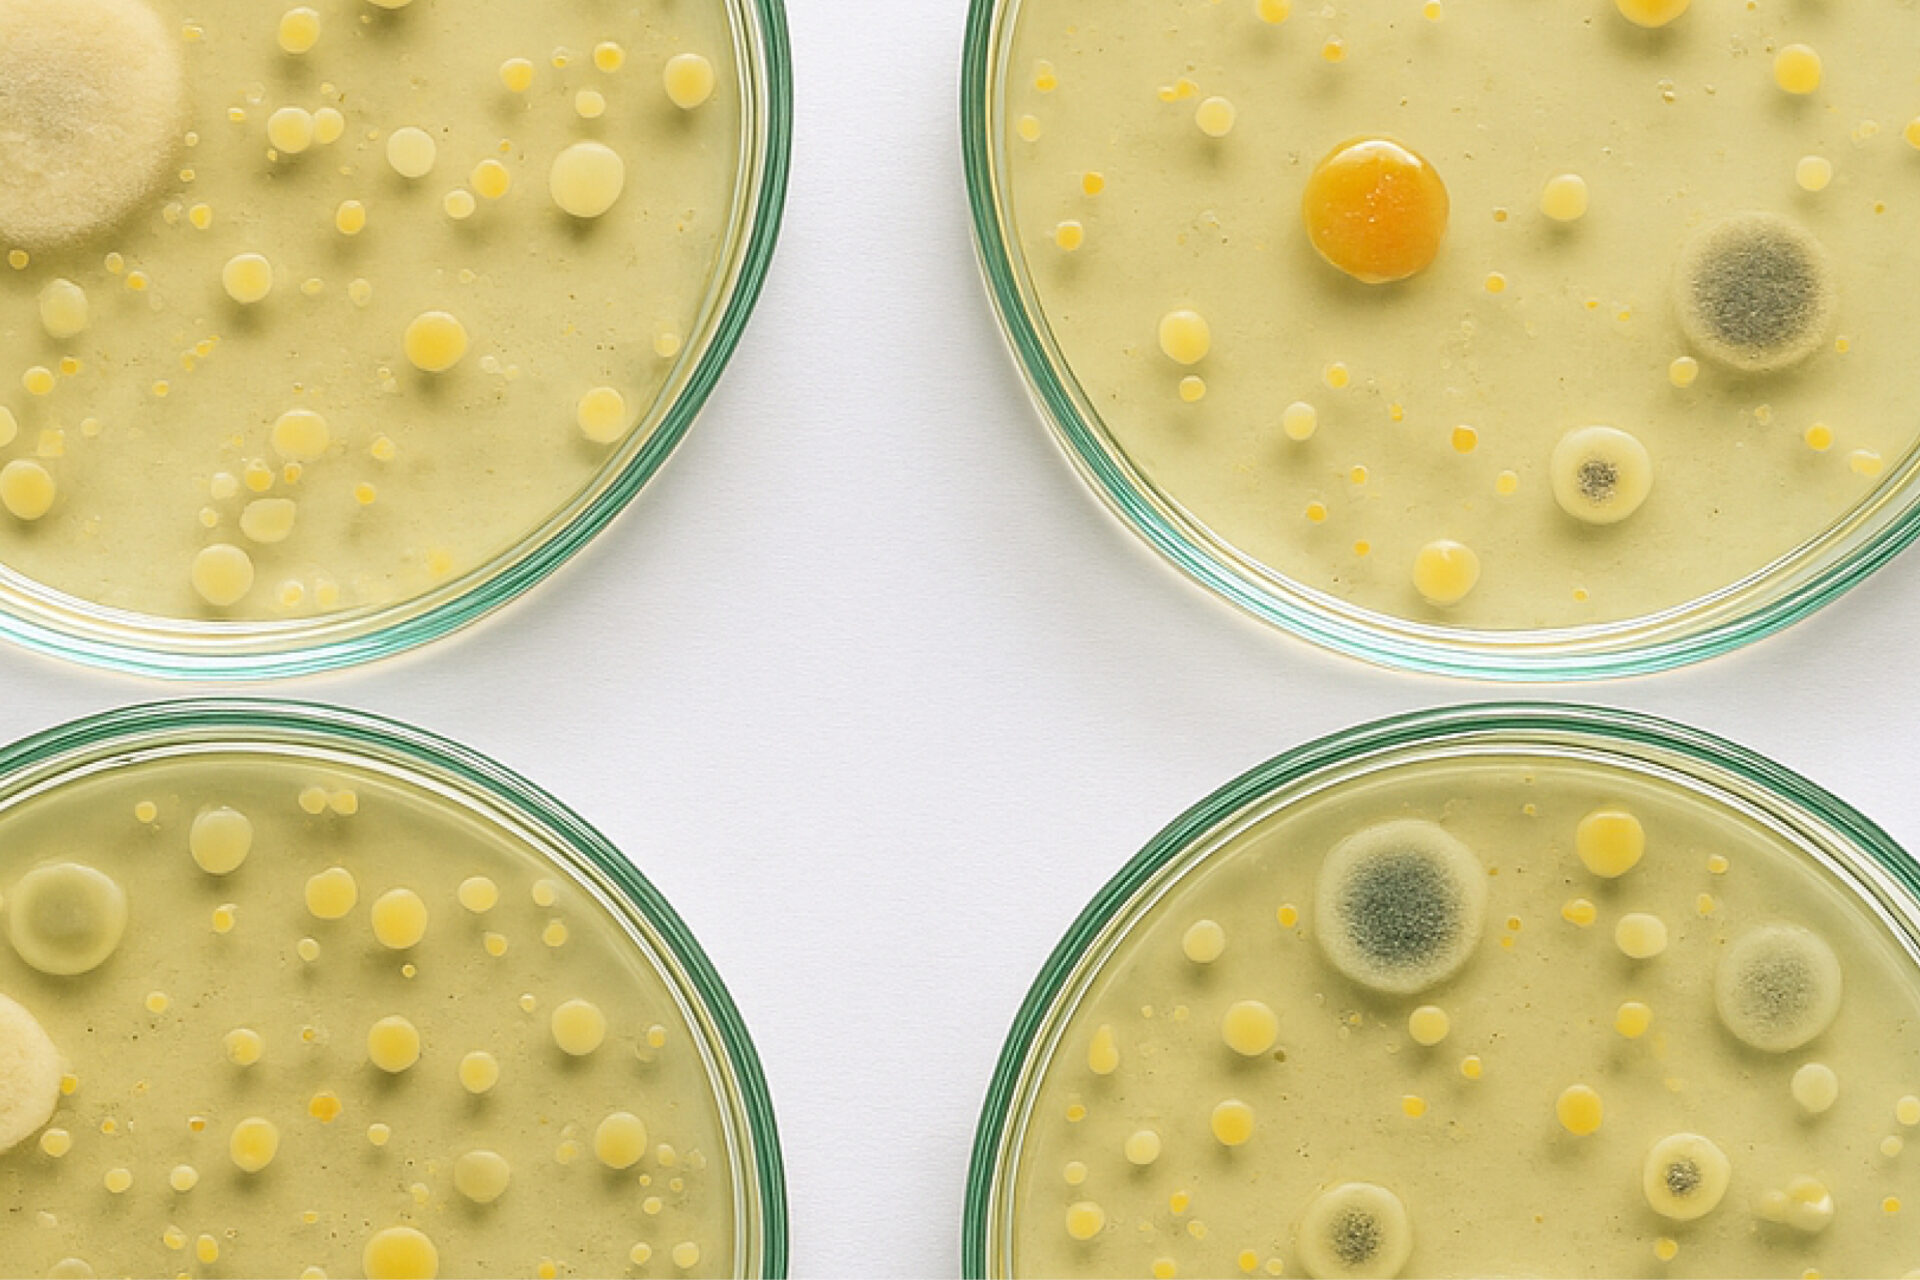

Solicitada la acreditación


Una de las barreras más importantes en la defensa de agentes externas del organismo es la microbiota. En este curso se profundizará de manera específica en la salud íntima femenina y la microbiota vaginal. Esta juega un papel muy importante en la salud de la mujer, no obstante su composición puede ser alterada por diferentes factores como la edad, el ciclo menstrual, el embarazo, el comportamiento sexual o los hábitos de higiene.
Las infecciones vulvovaginales tienen una elevada incidencia en la población femenina y pueden causar alteraciones y síntomas físicos y emocionales relevantes en la mujer. La vulvovaginitis per cándida o la vaginitis bacteriana son ejemplo de infecciones de muy elevada prevalencia que hay que diagnosticar a tiempo y tratar de manera rápida.
El profesional sanitario de la oficina de farmacia tiene un papel fundamental en la detección precoz, valoración de síntomas y abordaje del tratamiento, que son esenciales para una buena resolución de la patología. Del mismo modo, es el perfil sanitario indicado para promover la educación en la salud e higiene íntima con el fin de prevenir estas infecciones y reducir las recidivas.
Farmacéuticos/as.
El curso tiene como objetivo revisar las patologías vulvovaginales más frecuentes, su abordaje desde la oficina de farmacia y las estrategias para prevenirlas mediante una higiene íntima adecuada. Mas concretamente:
Acceso libre y flexible a los contenidos del curso para aprender a tu ritmo con total autonomía. Incluye vídeos y materiales didácticos interactivos que facilitan la comprensión y retención de los contenidos.
Combina el contenido teórico con un abordaje práctico a través del repaso de videos de expertos, resolución de casos prácticos autoformativos, contenido multimedia y el aprendizaje colaborativo entre los participantes a través de los foros de discusión.
Para superar el curso, deberá revisarse el 100% contenido, participar en los foros de discusión, completar los casos prácticos y resolver los test de evaluación con un mínimo del 80% de aciertos.
El equipo técnico de Ágora te acompañará en el seguimiento del curso y resolverá las dudas técnicas que puedan surgir.

Farmacéutica, profesora asociada en Blanquerna – Universidad Ramon Llull.

Médico especialista en obstetricia y ginecología, Clínica Sagrada Familia, Barcelona.

Farmacéutico, especializado en salud pública y farmacoepidemiología, Analista de calidad y Evaluación sanitaria en HIQA, Dublín.

Farmacéutica, directora técnica del COF de Barcelona.
Opiniones
Descubre la opinión que nuestros alumnos tiene sobre nosotros y cómo han valorado el programa formativo
Es muy útil
Porque es un tema muy frecuente en la farmacia.
Aclara muchos conceptos, de medicación, posologia y en especial informa bien sobre los probióticos.
Lo recomendaría porque es bastante completo y práctico
Muy didáctico hace mucho incapié en datos clave para la farmacia
lo recomendaría porque en no demasiado tiempo se puede ser capaz de adquirir los contenidos claves para desarrollar una mejor atención farmacéutica en este tema.
Completó y bien organizado
Sí, aunque hay algunos conceptos que se repiten dentro del módulo, algunos conceptos que se dan por sabidos y deberían tener un boton de link y algunas explicaciones no muy claras.
Son consultas muy frecuentes

Mucha información interesante